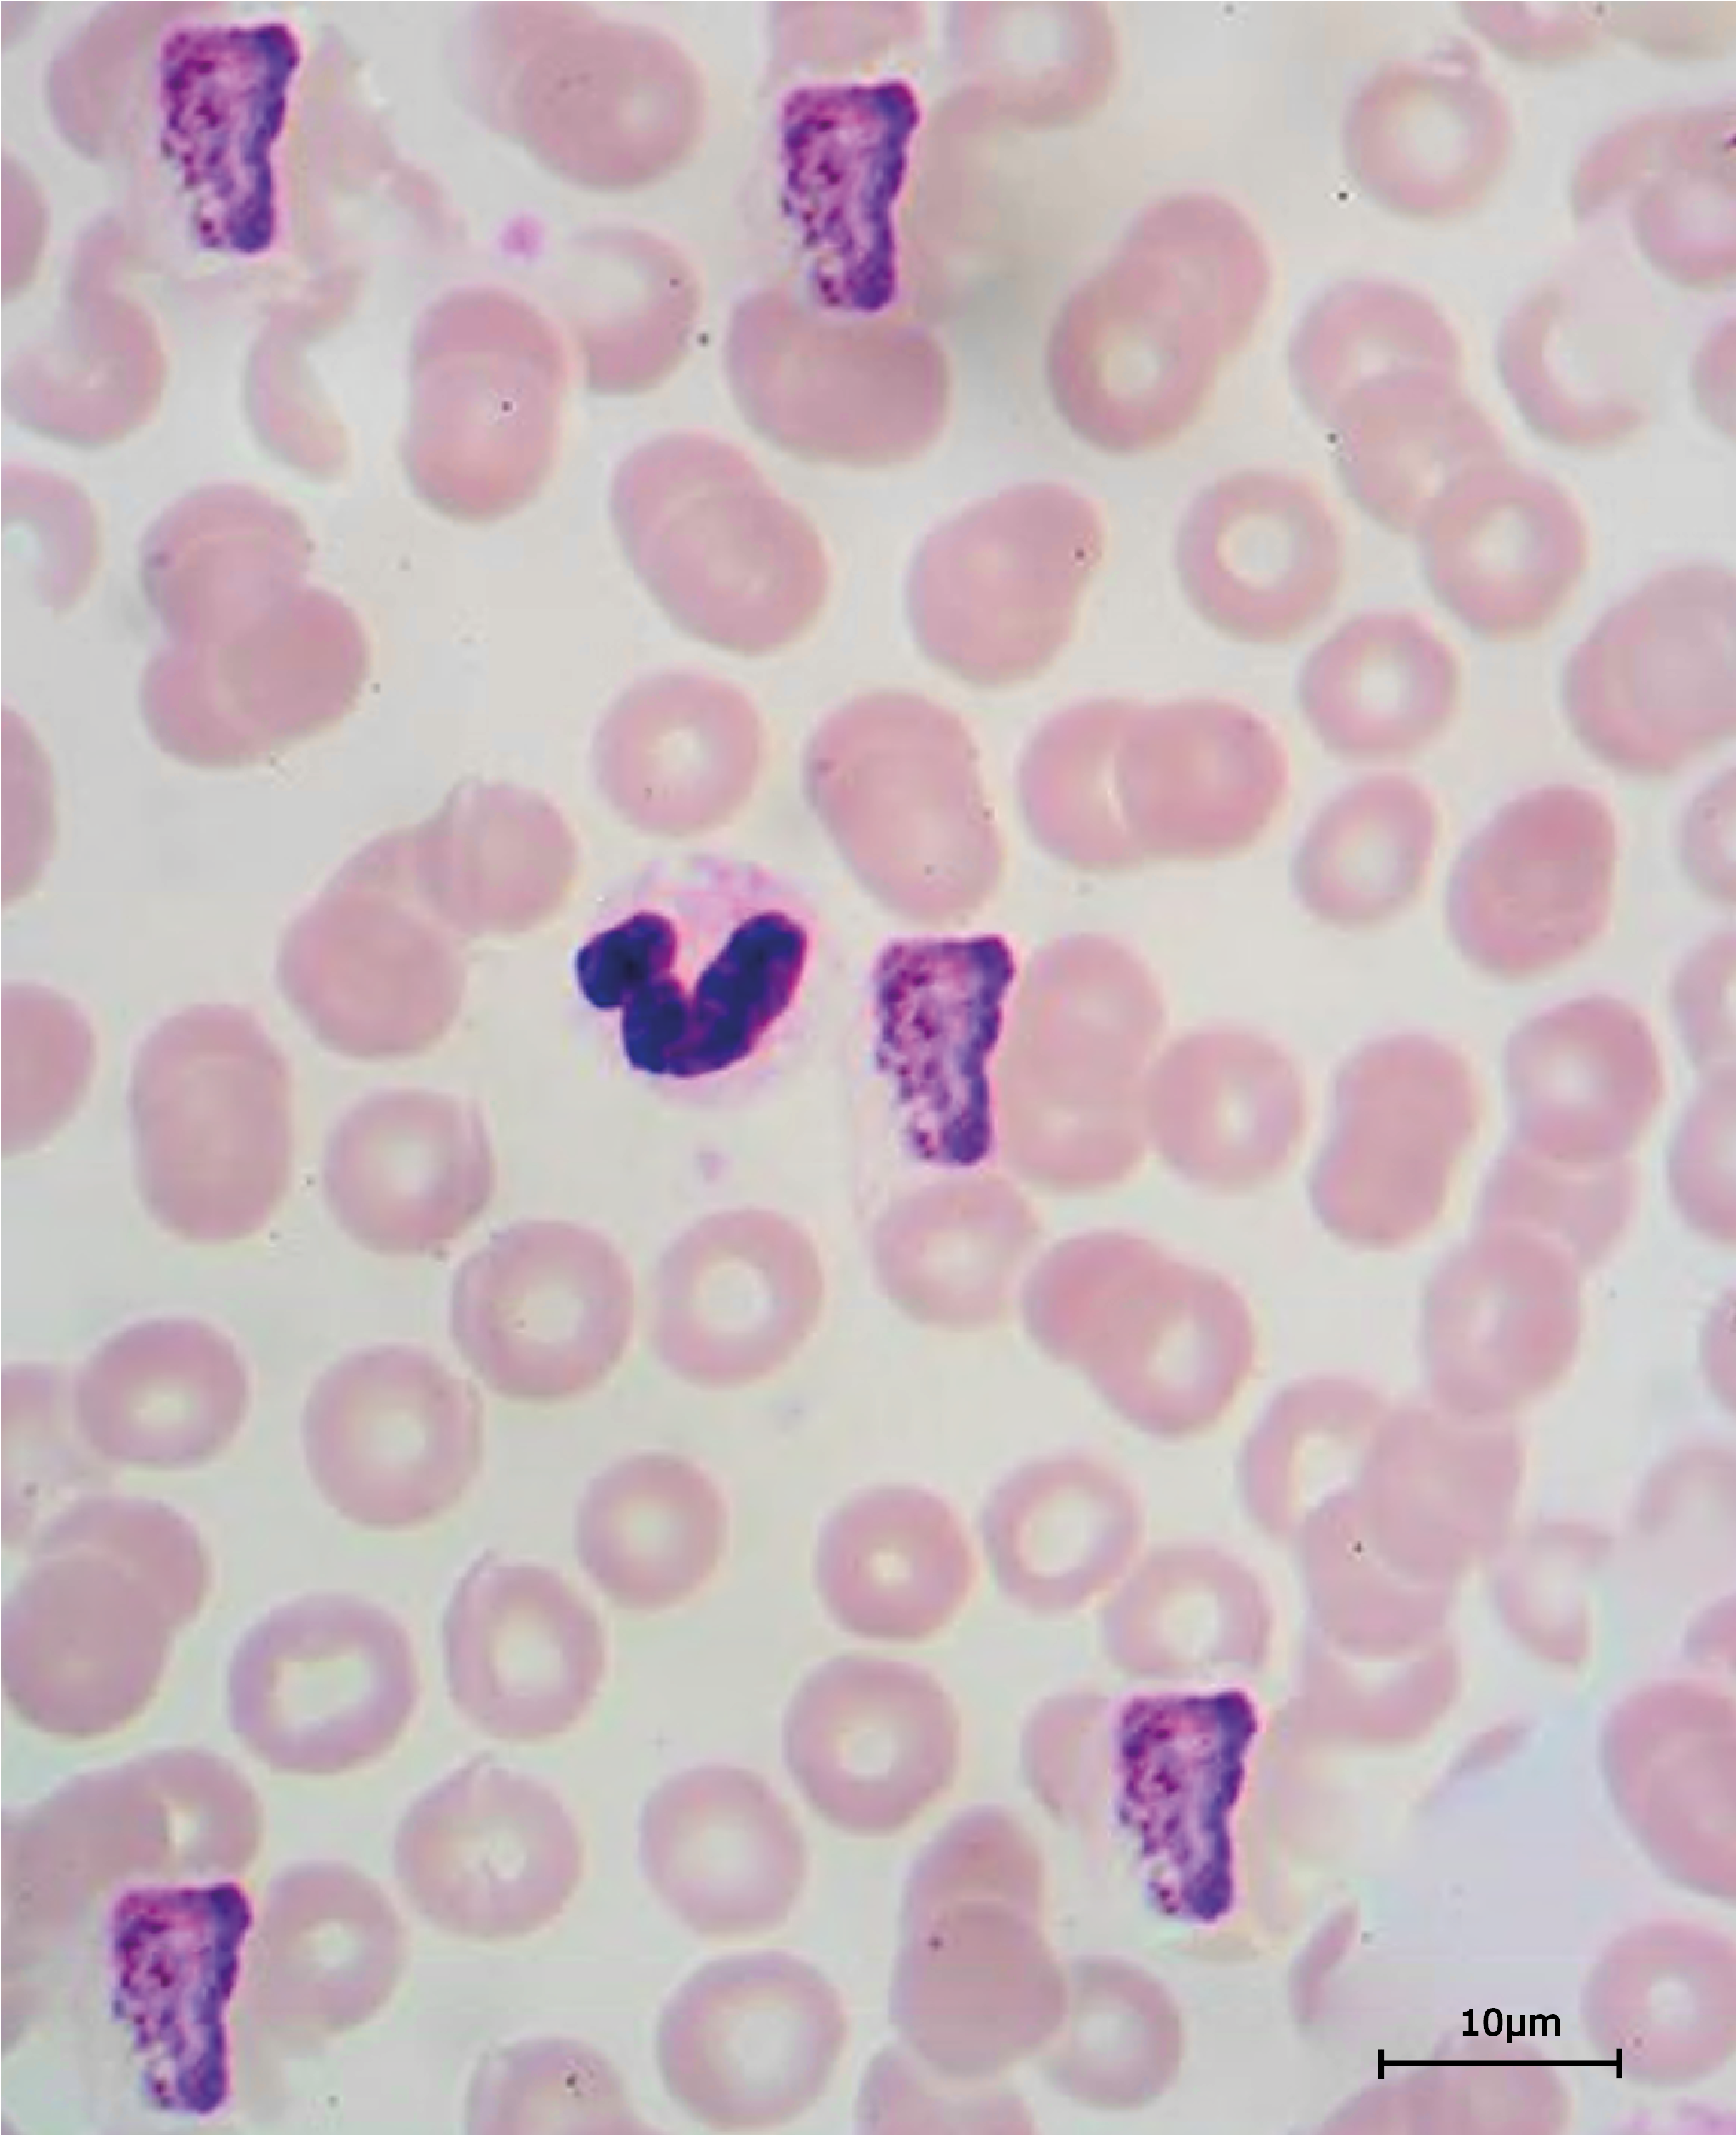
Malaria Blood Smear Scaled

This topic takes on average 45 minutes to read.
There are a number of interactive features in this resource:
 Human biology
Human biology
The protista consist of unicellular eukaryotic organisms which have a variety of methods of nutrition and reproduction. These single celled organisms come in an enormous range of shapes and lifestyles: from amoeba to diatoms, including plant-like cells that swim, animal-like cells that cannot move, cells that are shaped like bells or fans or shells - some may even be grouped into colonies. Within the protista are organisms which make up the greater part of the plankton of the oceans, and a few which cause some of the most serious diseases to affect the human race. In some ways the kingdom of the protista contains all the organisms which scientists are not able to classify into one of the other kingdoms.


The protozoa are one group of the protista and it is largely members of the protozoa that cause human diseases. They all act as parasites, and many of them involve other species for part of their life cycle, which is how they move from host to host. Human diseases caused by protozoa include:
Malaria is a disease which affects hundreds of millions of people world-wide and kills up to a million people each year, many of them are children under 5 years old. The main economic impact is that many young adults are affected and weakened by this disease. They cannot work effectively and this in turn has an impact on the economy of the individuals and the country.
The lifecycle of the malaria parasite involves two hosts, the Anopheles mosquito and people. The stages of the lifecycle which occur within the human body involve the lysis of large numbers of red blood cells and the associated disease symptoms of fevers, sweating, shaking with long-term weakness, anaemia and eventually death. The disease can be treated and prevented, although neither method is perfect. Controlling the mosquitoes that carry malaria and preventing them from biting people are the best ways of overcoming the disease. Simple measures such as using insecticide-impregnated mosquito nets have been successful at reducing the number of people affected by malaria in many countries.
There have been many attempts to find an effective vaccine, but up until now this has not been successful, partly because the protozoans hide inside the host cells. In 2015 the first human vaccine against malaria was launched. Scientists hope it will provide some protection for babies and small children and reduce deaths from the disease.

Not all of the parasites that cause disease in humans are microscopic. In many countries, parasitic worms cause a significant burden of disease. Worms are important animals – they play a major role in decomposition and the maintenance of healthy soil. However some types of worm can cause serious human diseases. Many of them damage the gut or other organs of the body, and they also take their food from the digestive system or body of their host. For example:

Globally, around 120 million people are affected by lymphatic filariasis
(Photo credit CDC)
Parasitic worms have adaptations that protect them against attack by the body of the host – the tapeworm is a very good example of this, with many adaptations on the head for attachment to the host, and a reproductive system that does not depend on mating so a constant supply of eggs are shed from the body of the host.


Bacteria, viruses, fungi, protista and other parasites all cause communicable diseases. Around 40% of deaths globally result from these communicable diseases – the other 60% are caused by non-communicable diseases such as heart disease, cancers and malnutrition.

Investigate one of the major parasitic diseases that affect people globally and compare it to a common bacterial disease. Using the information you collect prepare a poster to argue the case for more research into effective treatments for the parasitic disease you have chosen, highlighting the problems as well as the possibilities of treatment regimes.
